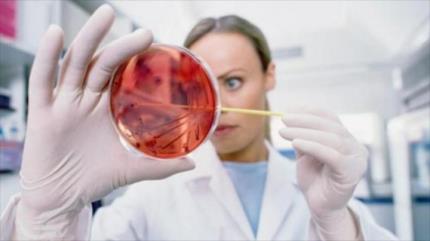

ONUSIDA
-
Dos personas con VIH se curan espontáneamente
Se han registrado dos casos en que personas infectadas con el VIH han logrado curarse, informa el rotativo venezolano Noticias24.
-
Jefe de ONUSIDA: El mundo espera acabar con el sida en 2030
El mundo se ha mostrado decidido a poner fin a la epidemia del sida para 2030. El plan forma parte de los Objetivos de Desarrollo Sostenible, dice ONUSIDA.
-
ONU: Se duplica número de enfermos de sida con antirretrovirales
El número de enfermos de sida con tratamiento de antirretrovirales (ARV) se ha duplicado en cinco años, para llegar a 18,2 millones de personas.
-
La ONU urge acelerar lucha contra el sida
La Organización de las Naciones Unidas (ONU) llamó al mundo a llevar a cabo un cambio radical durante los próximos cinco años para conseguir terminar con la epidemia del sida de aquí a 2030.
-
Irán se une a programa de la ONU para acabar con epidemia de sida
Irán se ha unido a un programa internacional para poner fin a la epidemia del sida en 2030, han informado autoridades del país persa.
-
Descubren en humanos una proteína inhibidora del VIH
Investigadores del Instituto Nacional de Infecciones de Japón han descubierto que una proteína hallada en humanos tiene efectos inhibidores sobre el virus de inmunodeficiencia humana (VIH).
-
ONUSIDA: Cuba logrará nuevas generaciones sin VIH
El director ejecutivo de ONUSIDA, Michel Sidibé, afirmó el viernes que Cuba es ejemplo de cómo se pueden lograr nuevas generaciones sin VIH.
-
Habrá tratamiento inyectable contra sida a partir de 2016
El tratamiento inyectable contra el sida podría ser administrado a partir del próximo año, afirmó el miércoles el director ejecutivo de la Agencia de las Naciones Unidas contra el Sida (ONUSIDA), Michel Sidibé.
-
Las muertes por VIH bajan un 31% en Latinoamérica
Un informe realizado por ONUSIDA revela que los datos de nuevas infecciones en Latinoamérica han registrado una caída del 3 % entre 2005 y 2013, mientras que en fallecimientos por la enfermedad, el descenso ha sido del 31 %.
-
El Salvador se acerca a eliminar la transmisión vertical VIH
El país ha logrado resultados importantes en la respuesta al VIH, según el director regional de la Agencia de las Naciones Unidas contra el Sida (ONUSIDA) para América Latina, César Núñez, en su reciente visita a tierras salvadoreñas, principalmente en el tema de la reducción de la transmisión de madre a hijo.
-
Nuevo medicamento para VIH aumenta expectativa de vida hasta 69 años
El medicamento funciona como un inhibidor de la enzima integrasa, impide que el ADN del virus del VIH se adhiera al de la célula sana y bloquea un paso fundamental en el ciclo de la replicación de éste.
-
ONU alerta de consecuencias catastróficas de un rebrote del sida
La ONU insta a los gobiernos a hacer un esfuerzo urgente contra el sida, en especial en los países más azotados por la enfermedad para evitar que vuelva a ganar terreno en los próximos años.